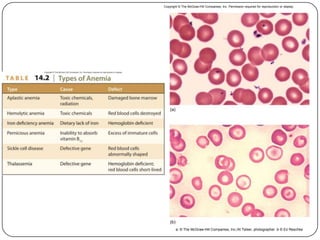
(b)
(a)
a: © The McGraw-Hill Companies, Inc./Al Telser, photographer :b © Ed Reschke
Copyright © The McGraw-Hill Companies, Inc. Permission required for reproduction or display.
53

The lecture by Dr. Wilma Bunayog focuses on blood physiology, detailing the composition, functions, and production of blood cells, particularly red blood cells and plasma. Key functions include the transport of gases and nutrients, regulation of pH and temperature, and protection against infection. It also discusses disorders such as anemia and polycythemia, highlighting their effects on the circulatory system.